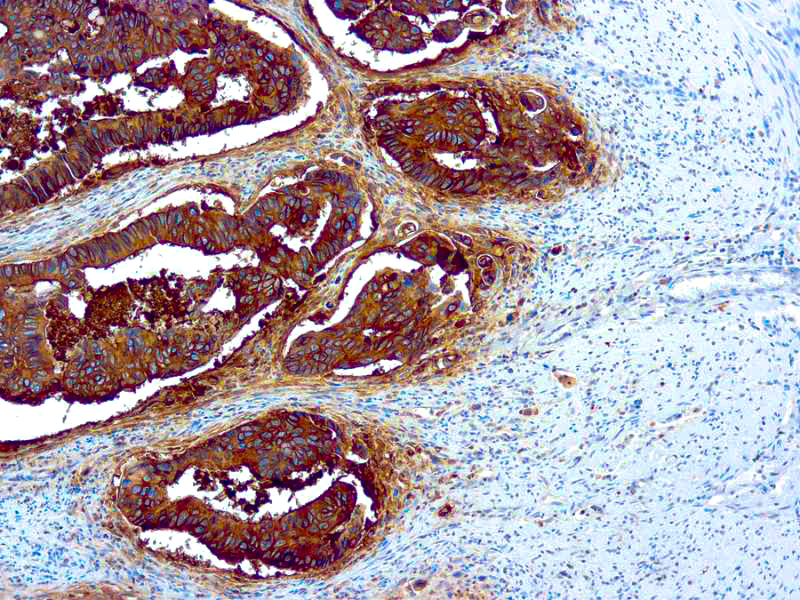

This antibody is a member of a family of complex antigens, which also includes non‐specific cross‐reacting antigens (NCA). This antibody stains specific regions of CEA. It reacts with colorectal adenocarcinomas but does not show any staining with polymorphonuclear neutrophils and erythrocytes.
Carcinoembryonic Antigen (CEA)
SKU: 8605
Categories: Primary Antibodies, IVD - For U.S. Market, IVD - Outside U.S. Market
Tags: Concentrated, C, Highlighter Product, HL72K-Core Kit
Description
Additional information
| Clone | COL-1 |
|---|---|
| Isotype | IgG2a, kappa |
| Immunogen | BALB/C mice were injected with extract of colon carcinoma cells. |
| Species | Mouse |
| Cellular Localization | Cytoplasmic and lumenal membrane |
| Positive Control Tissue | Colon carcinoma |
| Pretreatment | Citrate Buffer pH 6.0 (Manual/ Montage) |
| Incubation & Temperature | 30 min @ RT |
| Intended Use | IVD |
| Detection System | PolyVue™ Plus – Two Step Detection System or Montage PolyVue Plus™ Auto Detection System for Montage 360 System or HighLighter core kit for HighLighter Staining System |
| Description/Type | Mouse Monoclonal Antibody |
| Format | This product is supplied as a tissue culture supernatant and contains sodium azide as a preservative. |
DATASHEETS & SDS
DATASHEETS & SDS
| Download Datasheet |
| Download SDS Sheet – OSHA |
REFERENCES
REFERENCES
- Albers et al. Am J Pathol 90: 17, 1988.
- Ellis et al. J Clin Pathol 41: 1064, 1988. Oikawa et al. Biochem
- Biophys Res Commun 144: 634, 1987.
- Pfaltz et al. Virchows Arch A 411: 387, 1987.
Reviews (0)
Only logged in customers who have purchased this product may leave a review.

Reviews
There are no reviews yet.